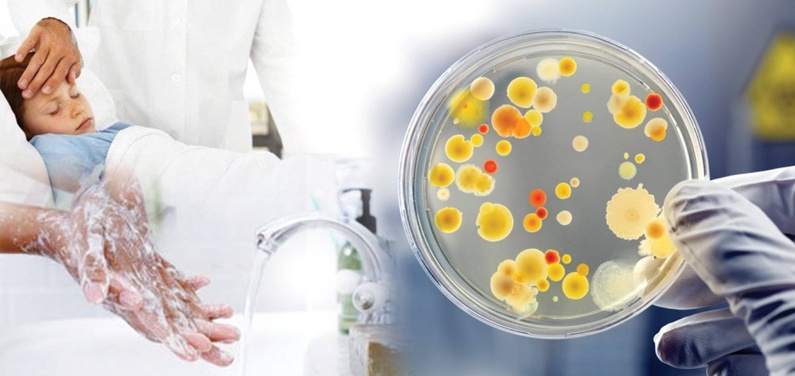
salmon2023

Во многих странах сальмонеллез является проблемой здравоохранения, и наносит ощутимый экономический ущерб. В нашей стране сальмонеллез – первый по распространенности зооантропоноз (инфекционное заболевание общее для человека и животных), распространен среди диких и домашних животных, особенно среди тех, мясо которых используется людьми в пищу (птица, свиньи и крупный рогатый скот). Нередко встречается среди домашних питомцев, включая кошек, собак, ежей, птиц и даже рептилий, таких как черепахи и ящерицы. Животные в большинстве случаев переносят заболевание легко или бессимптомно.
Возбудитель сальмонеллеза – бактерия сальмонелла – очень устойчива во внешней среде, относительно не прихотлива и может обнаруживаться на протяжении всей пищевой цепи человека – от корма для животных, первичного производства продуктов питания и до готовых блюд дома или на предприятиях общественного питания.
Заражение людей, как правило, происходит в результате употребления в пищу продуктов животного происхождения (в основном яиц, мяса, домашней птицы и молока), хотя фактором передачи может быть любой продукт. Так, плохо вымытые или обработанные натуральными животными удобрениями пищевые продукты, включая зелень и овощи, тоже могут стать фактором передачи инфекции. Особая роль в механизме передачи принадлежит рукам, особенно при приготовлении пищи. При попадании на них сальмонелл, заражается готовая пища, что в конечном итоге может привести к заболеванию сальмонеллезом всех людей, которые ее употребят.
Динамика эпидемического процесса сальмонеллеза в республике на протяжении последних 20 лет характеризуется умеренной тенденцией к снижению с колебанием показателей заболеваемости в пределах – 30-55 случаев на 100 тысяч населения. В 2022 году показатель заболеваемости остался на уровне 2021 года и составил – около 25 случаев на 100 тысяч населения. В микробном пейзаже сальмонелл ежегодно циркулирует более 40 серотипов, однако, наибольшее число заболеваний (более 78%) обусловлено серотипом S. enteritidis.
Возрастной диапазон заболевших сальмонеллезом в стране широкий – от новорожденных до пожилых людей старше 90 лет, однако чаще заболевание возникало среди детей (53,8% от общего числа зарегистрированных случаев). Группой риска по возникновению заболевания являлись дети в возрастной когорте – 1-6 лет.
Среди взрослых от 18 до 69 лет заболеваемость распространена равномерно с незначительным преобладанием процента случаев в возрастной группе 18-29 лет. Вклад в возрастную структуру заболеваемости сальмонеллеза лиц пенсионного возраста минимальный – до 6% случаев, вместе с тем у них заболевание протекает тяжелее.
Городское население болеет чаще, более 85% случаев регистрируется среди жителей городов. Традиционно более высокие уровни заболеваемости в областных центрах и столице, где регистрируется 57,4% случаев заболеваний от общего числа зарегистрировано в республике. Такое распределение обусловлено, рядом причин, в том числе высокой централизацией производства продовольственного сырья и пищевых продуктов, плотностью населения, а также развитой сетью общественного питания, стереотипами пищевого поведения и различиями в обращаемости за медицинской помощью.
Эпидемиологическое расследование в очагах сальмонеллезов позволило установить путь передачи инфекции для 96,6% случаев, из них подавляющее число случаев (92,7%) заражения происходило посредством пищевого пути передачи инфекции, что согласуется с данными микробиологического мониторинга. Так, в 2022 году при исследовании проб продовольственного сырья и пищевых продуктов чаще сальмонеллы находили в пробах мяса и мясных продуктов (64% от общего числа положительных), яиц и яичной продукции (21% от общего числа положительных). В 3,9% случаев инфекция реализовывалась контактно-бытовым путем. Как, правило, посредством контактно-бытовой передачи заражение осуществлялось по причине пренебрежения мерами личной гигиены в уходе за маленькими детьми.
Как отмечалось выше, сальмонеллы достаточно устойчивы в окружающей среде. Могут сохранять жизнеспособность в воде до 5 месяцев, в почве до полутора лет, в мясе до полугода, в птичьих тушках до года и более. Около 20 дней сохраняются в молоке, месяц в кефире и четыре месяца – в сливочном масле. В сыре сальмонелла может оставаться в живом виде до года, 3-9 месяцев в яичном порошке и 17-24 дня на скорлупе яиц. Сальмонеллы погибают спустя 5-10 минут при температуре 70°С. Могут выдерживать некоторое время кипячение, если находятся в толще крупного куска мяса. При варке яиц погибают через 4 минуты. В молоке и мясных продуктах сальмонеллы не только сохраняются, но и активно размножаются, при этом, не влияя на органолептические свойства (цвет, вкус, запах) продуктов. Микроорганизмы довольно устойчивы к солению и копчению, а при заморозке увеличивают длительность срока жизни. Кроме того, в настоящее время в циркуляции присутствуют резидентные штаммы сальмонелл, имеющие высокую степень устойчивости к антибиотикотерапии и дезинфицирующим средствам.
Благодаря этому в передаче заболевания участвуют множество факторов, однако из года в год есть среди них лидеры – это яйца и блюда из них, блюда из мяса птицы, готовые мясные изделия. Эпидемиологическая значимость остальных факторов передачи – значительно ниже. Наиболее частой причиной заражения являлась недостаточная термическая обработка продуктов, а также употребление в пищу сырых яиц.
В большинстве случаев (более 90%) заражение пациентов происходит по месту жительства. Как правило, в очагах инфекции отмечаются единичные или несколько одномоментно возникших случаев сальмонеллеза. Периодически отмечаются вспышки сальмонеллеза, как правило, они носят локальный характер и быстро купируются путем проведения санитарно-противоэпидемических мероприятий, которые организуют учреждения санитарно-эпидемиологической службы.
Вопросы организации санитарно-противоэпидемических мероприятий в отношении сальмонеллезных инфекций определяются санитарными нормами и правилами «Требования к порядку организации и проведения санитарно-противоэпидемических мероприятий, направленных на предотвращение заноса, возникновения и распространения кишечных инфекций», утвержденными постановлением Министерства здравоохранения Республики Беларусь от 25.01.2023 г. № 14.
В целях снижения заболеваемости и недопущения распространения сальмонеллезных инфекций принципиально важным является соблюдение санитарно-эпидемиологических и санитарно-ветеринарных требований на всех этапах пищевой цепочки, от сельскохозяйственного производства до переработки, производства и приготовления пищевых продуктов, как на объектах (предприятия пищевой промышленности, учреждения торговли и общественного питания, учреждения образования и др.), так и в домашних условиях.
Из общих профилактических мер заражения сальмонеллезом для каждого человека необходимо отметить следующее:
- мытье рук с мылом, особенно, после контакта с домашними или сельскохозяйственными животными, посещения туалета, перед едой и т.д.;
- правильное приготовление пищи (с достаточной термической обработкой) с использованием кухонного инвентаря раздельно для сырой и готовой пищи;
- соблюдение правил хранения скоропортящейся пищи (только в условиях холодильника с соблюдением сроков, указанных производителем на этикетке), отдавать предпочтение приготовлению пищи на один прием. В холодильнике отдельно хранить готовую и сырую продукцию;
- тщательная обработка яиц перед употреблением – промыть их под проточной водой, варить не менее 10-15 минут, яичницу или омлет лучше обжаривать с двух сторон. Не употреблять сырые яйца, если нет уверенности в их безопасности;
- не «снимать пробы» с сырой продукции или полуфабрикатов, особенно животного приготовления (маринованное мясо, фарш и др.), в том числе с прилавка в магазине или на рынке;
- употребление только пастеризованного или кипяченого (если оно домашнее) молока;
- употребление питьевой воды гарантированного качества и исключение применения (употребления) льда, если он не сделан из безопасной воды;
- тщательное мытье фруктов и овощей.
Следуйте простым советам и будьте здоровыми!
С сайта ГУ «РЦГЭ и ОЗ»
